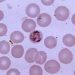
Experimental malaria vaccine confers modest, short-term protection

Patients at long-term increased mortality risk following stroke at young age
[tabs tab1=”2MM Rundown” tab2= “2MM Full Report”]
[tab]
Image: PD
1. As the majority of strokes occur in elderly patients, little is known about the long-term prognosis of strokes in younger patients.
2. Patients aged 18 to 50 suffering from strokes are at increased risk of death both in the acute post-stroke period and for decades to follow.
Published today, the present study presents long-term mortality data in survivors of young stroke. This population has been largely uninvestigated to date, as they only represent approximately ten percent of stroke patients. On the other hand, these patients also have a longer life expectancy and as such represent a larger proportion of person-years at risk for post-stroke mortality. The authors confirm that these patients are at increased mortality risk immediately following their stroke, while further demonstrating that this risk is carried far beyond the acute post-stroke period.
This study is limited primarily by the selection bias inherent in a single-site design, as only patients referred to a major university medical center were included, which may bias case selection toward more severe strokes. Additionally, the demographics of the stroke and control populations, while representative of the Netherlands general population, may not be generalizable to patients worldwide. That said, this remains one of the most comprehensive and long-term studies of the young stroke population to date and should certainly inform current practice and future investigations.
Click to read the study, published today in JAMA
[/tab]
[tab]
Image: PD
1. As the majority of strokes occur in elderly patients, little is known about the long-term prognosis of strokes in younger patients.
2. Patients aged 18 to 50 suffering from strokes are at increased risk of death both in the acute post-stroke period and for decades to follow.
This [prospective cohort] study: Long-term follow-up data was obtained from 959 participants in the Follow-Up of Transient Ischemic Attack and Stroke Patients and Unelucidated Risk Factor Evaluation (FUTURE) study, which enrolls patients following a “young stroke”, defined as aged 18 to 50 presenting with first-time transient ischemic attack (TIA), ischemic stroke, or intracerebral hemorrhage (ICH). The mean age of stroke was 40.1 years, with a mean follow-up of 8.3 years. When compared with age- and sex-matched controls, young stroke patients had a 3.5-fold increased mortality risk within the first 30 days of the stroke (p<0.001). Patients who survived an ischemic stroke or TIA beyond the first 30 days continued to carry increased mortality risk, though this normalized to that of the general population following ICH. The cause of death was vascular (either second stroke, cardiac, or other vascular events) in half of the 30-day survivors, with the remainder succumbing primarily to malignancies or infection.
In sum: The present study presents long-term mortality data in survivors of young stroke. This population has been largely uninvestigated to date, as they only represent approximately ten percent of stroke patients. On the other hand, these patients also have a longer life expectancy and as such represent a larger proportion of person-years at risk for post-stroke mortality. The authors confirm that these patients are at increased mortality risk immediately following their stroke, while further demonstrating that this risk is carried far beyond the acute post-stroke period.
This study is limited primarily by the selection bias inherent in a single-site design, as only patients referred to a major university medical center were included, which may bias case selection toward more severe strokes. Additionally, the demographics of the stroke and control populations, while representative of the Netherlands general population, may not be generalizable to patients worldwide. That said, this remains one of the most comprehensive and long-term studies of the young stroke population to date and should certainly inform current practice and future investigations.
Click to read the study, published today in JAMA
By Jeff Dewey and Rif Rahman
More from this author: Longer-duration breast feeding not associated with lower risk of obesity in childhood, Aneurysm diameter useful in determining frequency of surveillance, Maternal folic acid supplementation during early pregnancy associated with lower risk of autism, Energy drinks may be harmful to the health of adolescents
© 2013 2minutemedicine.com. All rights reserved. No works may be reproduced without written consent from 2minutemedicine.com. Disclaimer: We present factual information directly from peer reviewed medical journals. No post should be construed as medical advice and is not intended as such by the authors or by 2minutemedicine.com. PLEASE SEE A HEALTHCARE PROVIDER IN YOUR AREA IF YOU SEEK MEDICAL ADVICE OF ANY SORT. Content is produced in accordance with fair use copyrights solely and strictly for the purpose of teaching, news and criticism. No benefit, monetary or otherwise, is realized by any participants or the owner of this domain.
[/tab]
[/tabs]